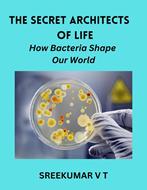
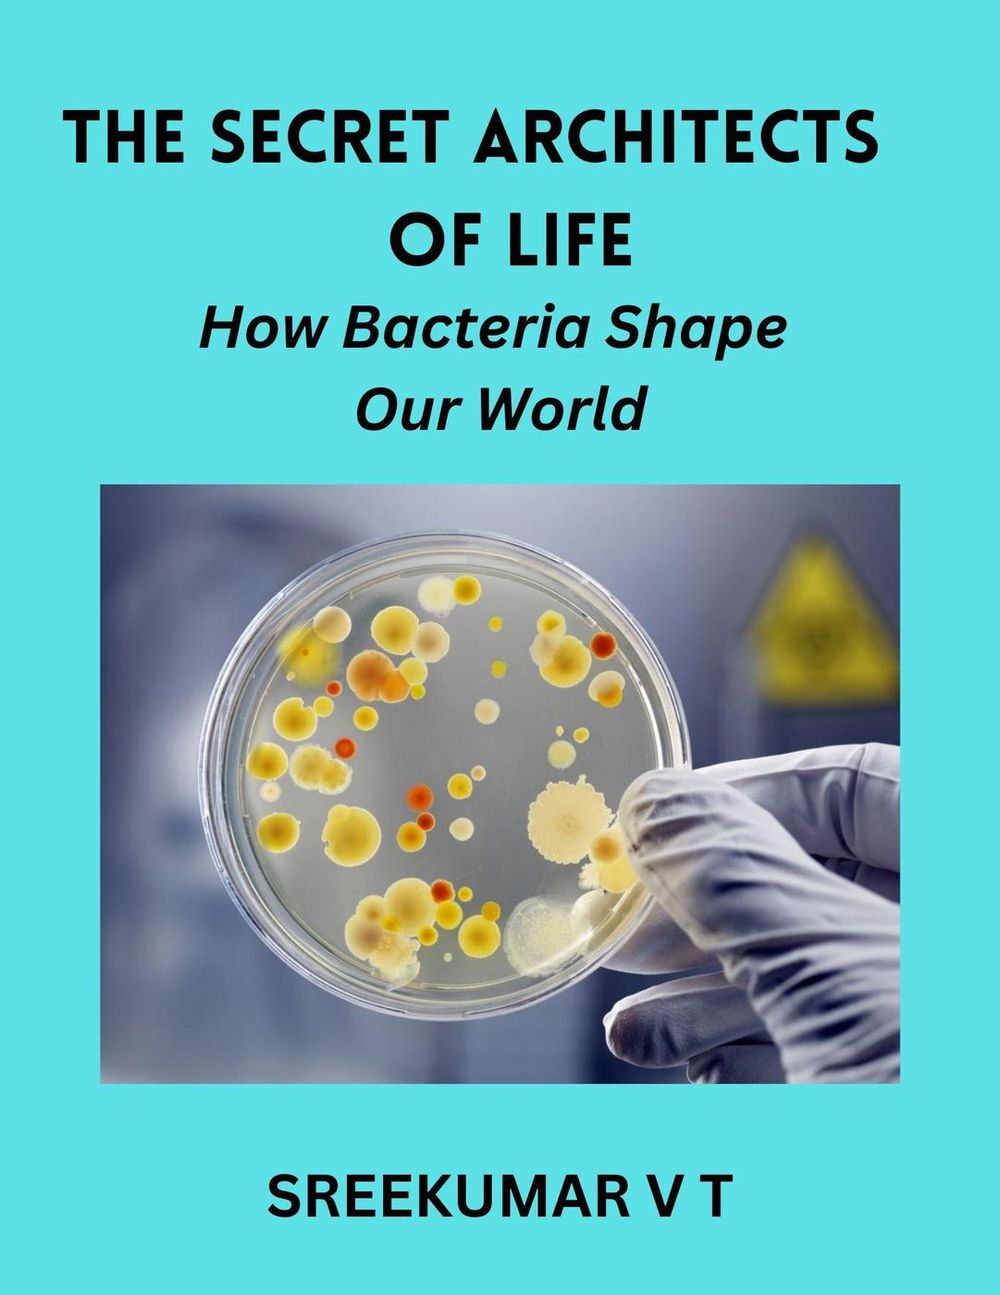
ibs

L’articolo è stato aggiunto alla lista dei desideri
IBS.it, l'altro eCommerce
The Secret Architects of Life: How Bacteria Shape Our World
Cliccando su “Conferma” dichiari che il contenuto da te inserito è conforme alle Condizioni Generali d’Uso del Sito ed alle Linee Guida sui Contenuti Vietati. Puoi rileggere e modificare e successivamente confermare il tuo contenuto. Tra poche ore lo troverai online (in caso contrario verifica la conformità del contenuto alle policy del Sito).
Grazie per la tua recensione!
Tra poche ore la vedrai online (in caso contrario verifica la conformità del testo alle nostre linee guida). Dopo la pubblicazione per te +4 punti
Altre offerte vendute e spedite dai nostri venditori

Tutti i formati ed edizioni
Promo attive (0)
Book Description: The Secret Architects of Life: How Bacteria Shape Our World by Sreekumar V T unveils the astonishing world of bacteria, showing readers that these microscopic organisms are far more than mere germs or unseen life forms. In this groundbreaking exploration, Sreekumar reveals how bacteria are the hidden engineers of life, silently orchestrating processes that sustain ecosystems, influence evolution, and support the health of every living organism on Earth. From the earliest moments of life's history, bacteria have been quietly transforming the planet. They have crafted our oxygen-rich atmosphere, recycled essential nutrients, and established symbiotic relationships that make life as we know it possible. In a style that is both accessible and scientifically rich, Sreekumar guides readers through the myriad ways that bacteria operate behind the scenes—reshaping soils, powering ecosystems, and even influencing our behavior and well-being. As our understanding of bacterial science advances, these tiny architects are being recognized not only for their historical roles but for their potential to shape the future. From combating climate change and cleaning up pollution to pioneering breakthroughs in medicine and biotechnology, bacteria are proving to be essential allies in solving some of humanity's most pressing challenges. Through The Secret Architects of Life, Sreekumar also invites readers to reflect on the ethical and ecological questions that arise as we begin to harness bacteria in unprecedented ways, manipulating their power to build a more sustainable future. Rich with insights from recent research and discoveries, The Secret Architects of Life is both a celebration of bacteria's extraordinary influence and a call to recognize their importance in our world. This book is perfect for readers fascinated by science, nature, and the intricate connections that weave together all life. Sreekumar V T's compelling work invites us to look closer at life's hidden architects and to appreciate the remarkable ways bacteria have shaped—and continue to shape—our world.
L'articolo è stato aggiunto al carrello
Formato:
Gli eBook venduti da IBS.it sono in formato ePub e possono essere protetti da Adobe DRM. In caso di download di un file protetto da DRM si otterrà un file in formato .acs, (Adobe Content Server Message), che dovrà essere aperto tramite Adobe Digital Editions e autorizzato tramite un account Adobe, prima di poter essere letto su pc o trasferito su dispositivi compatibili.
Cloud:
Gli eBook venduti da IBS.it sono sincronizzati automaticamente su tutti i client di lettura Kobo successivamente all’acquisto. Grazie al Cloud Kobo i progressi di lettura, le note, le evidenziazioni vengono salvati e sincronizzati automaticamente su tutti i dispositivi e le APP di lettura Kobo utilizzati per la lettura.
Clicca qui per sapere come scaricare gli ebook utilizzando un pc con sistema operativo Windows
L’articolo è stato aggiunto alla lista dei desideri

